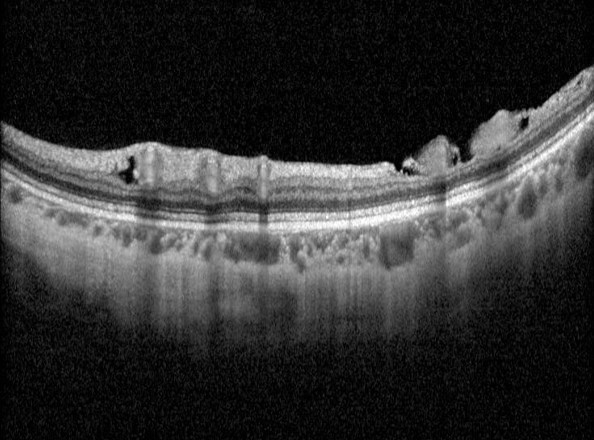

Overview
Myopic maculopathy may be associated with a range of changes related to the vasculature. The three key myopia-related changes are outlined here:
Paravascular cysts appear as small hyporeflective spaces around large retinal vessels. They typically in occur with patients of older age, higher myopia, longer axial lengths and with a posterior staphyloma.
Microfolds show a sharp peak located along a retinal vessel. Thought to develop due inflexibility of the retinal vessels and traction of the vitreous on the retina. The presence of a retinoschisis is higher if there are also coexisting paravascular cysts
Paravascular lamellar hole refers to a defect in the inner retinal layers around the retinal vessel. It is thought to arise from the ‘unroofing’ of a parasvascular cyst.
Examples
Differential Diagnosis
References
Ng, D., Cheung, C., Luk, F. et al. (2016) Advances of optical coherence tomography in myopia and pathologic myopia. Eye 30, 901–916
Yasushi, I. (2017) Overview of the complications of high myopia, Retina: Volume 37 - Issue 12 - p 2347-2351


